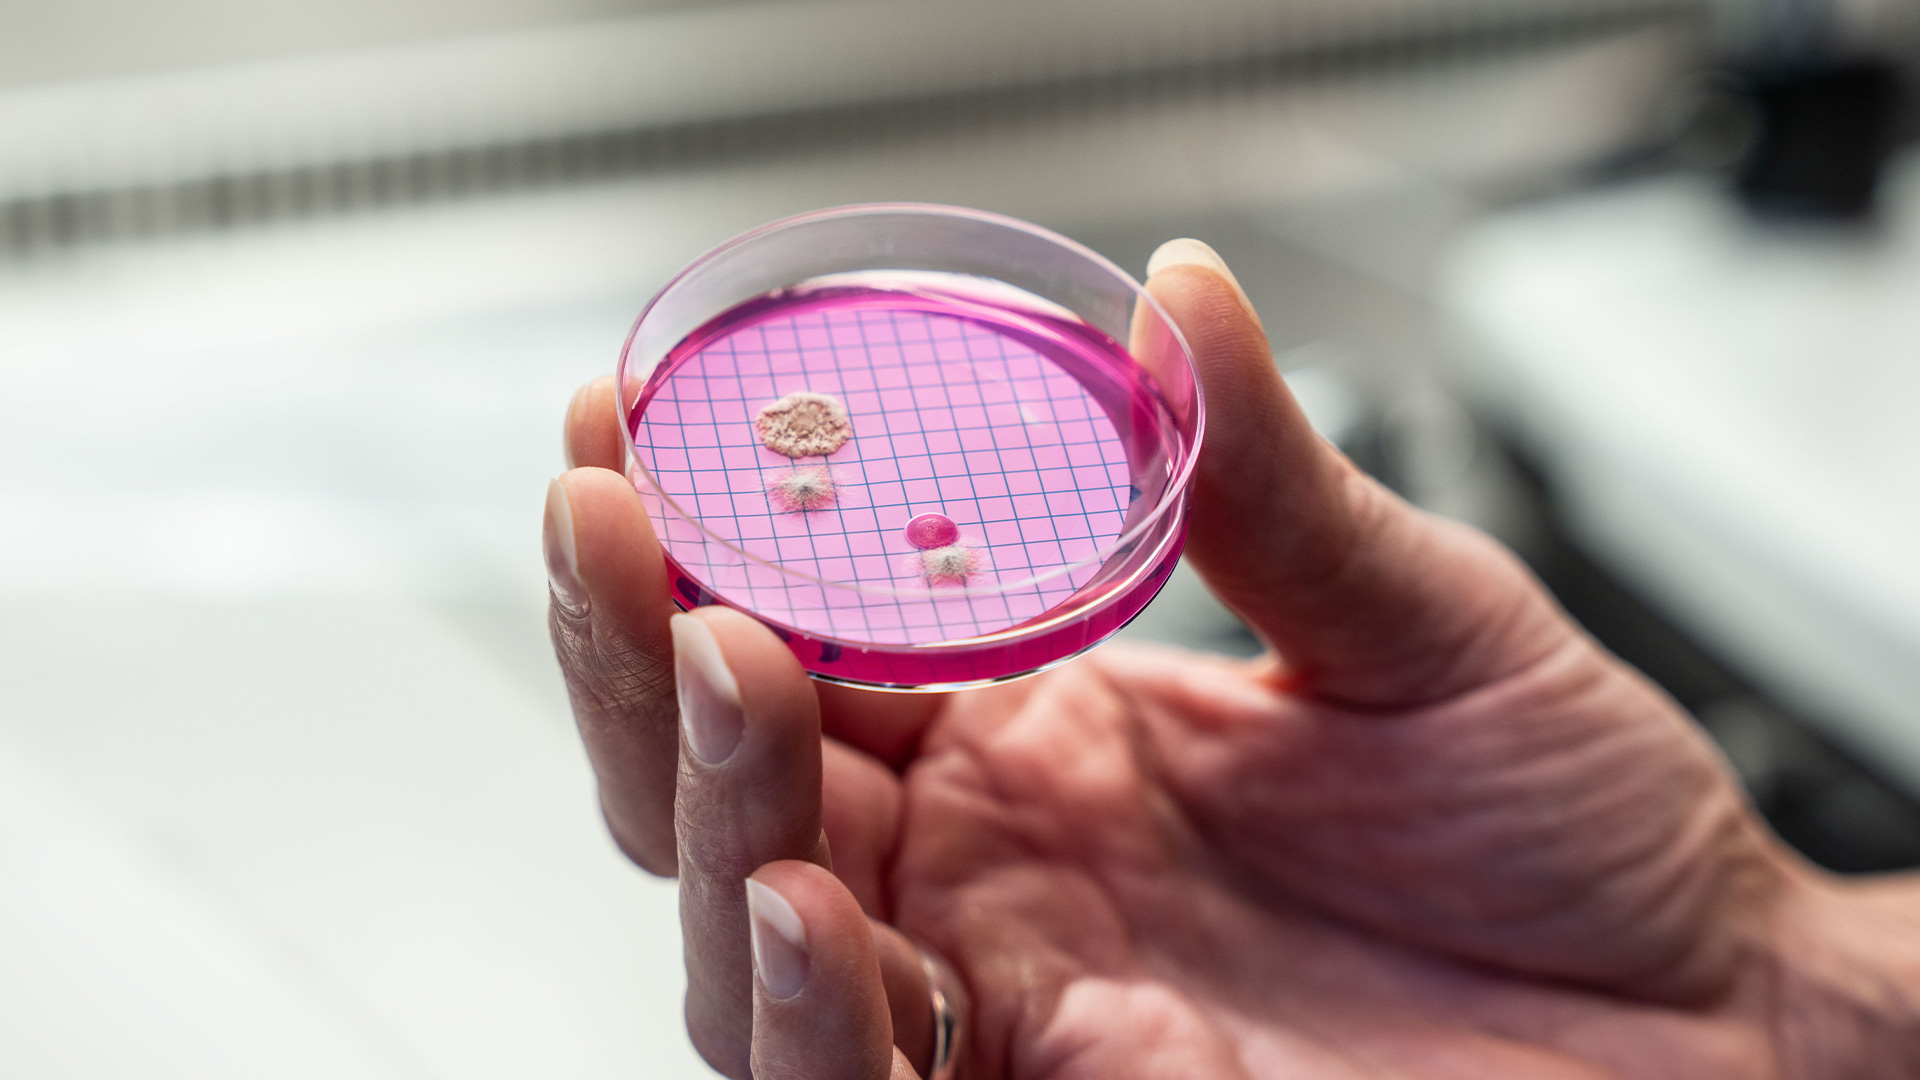
Bakterier

Källan till allt liv – vatten, vårt viktigaste livsmedel
Att arbeta med vatten och avlopp är ett kretsloppsarbete. Vi hämtar vårt råvatten från naturen och lämnar tillbaka det igen efter att vi använt och renat det. Men innan det sker noggranna kvalitetskontroller i flera led.
Här i Eskilstuna har vi fyra vattenverk som försörjer invånarna med dricksvatten. Det största är Hyndevads vattenverk och därifrån får de flesta sitt dricksvatten. Råvattnet till Hyndevads vattenverk hämtas från Hyndevadsån vid Hjälmarens utlopp i Mälaren. Ytvattnet från ån pumpas upp till en ås där det sedan sjunker genom marklagren. På så sätt påskyndas processen för ytvattnet till att bli grundvatten. Första reningen sköter alltså naturen. Vattnet kvalitetövervakas och testas kontinuerligt, både i det egna laboratoriet men också i externa specialiserade laboratorier.
Det ställs höga krav på reningen när dricksvatten produceras och det utgående dricksvattnet, som kommer ur din kran, testas regelbundet i laboratoriet på både mikrobiologisk och kemisk renhet. Maria Hakala, som är chef på vårt laboratorium, berättar hur det går till.
”Dricksvatten är klassat som ett livsmedel och kravet på renhet är väldigt högt. Provtagningen går helt enkelt till så att vi tar vattenprover från fasta och tillfälliga prov-tagningspunkter hos användare och analyserar dem.”
– Vi utför regelbundna kontroller på dricksvattnet i vattenverket men också ute på ledningsnätet. Dricksvatten är klassat som ett livsmedel och kravet på renhet är väldigt högt. Provtagningen går helt enkelt till så att vi tar vattenprover från fasta och tillfälliga provtagningspunkter hos användare och analyserar dem. Det sker rutinmässigt och styrs av ett program för regelbundna undersökningar.
Skulle det visa sig att någon bakterienivå är för hög måste en kokningsrekommendation utfärdas. Det innebär att man uppmanas att koka vattnet innan förtäring. Under en kokningsrekommendation inleds ett intensivt arbete med att lokalisera vad som orsakat bakterierna. Det är inte alltid man hittar svaret trots ett stort sökarbete.
– Det viktigaste är ändå att få vattnet rent igen. Det görs genom spolning av ledningarna och ibland kan vi också behöva öka klormängden i vattnet. Medan dessa insatser pågår tas mängder med prover. Det är först när vi har två på varandra efterföljande godkända prov som dricksvattnet är godkänt igen. Eftersom vissa prover också skickas till andra labb så kan det ta lite tid, berättar Maria.